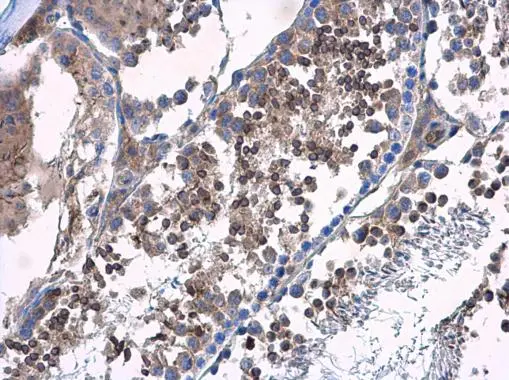
HOOK2 antibody detects HOOK2 protein at cytoplasm in mouse testis by immunohistochemical analysis. Sample: Paraffin-embedded mouse testis. HOOK2 antibody (GTX115898) diluted at 1:500. 
 Antigen Retrieval: Citrate buffer, pH 6.0, 15 min

HOOK2 antibody detects HOOK2 protein at cytoplasm in mouse duodenum by immunohistochemical analysis. Sample: Paraffin-embedded mouse duodenum. HOOK2 antibody (GTX115898) diluted at 1:500.
Antigen Retrieval: Citrate buffer, pH 6.0, 15 min
HOOK2 antibody
GTX115898
ApplicationsImmunoFluorescence, ImmunoPrecipitation, Western Blot, ImmunoCytoChemistry, ImmunoHistoChemistry, ImmunoHistoChemistry Paraffin
Product group Antibodies
ReactivityHuman, Mouse
TargetHOOK2
Overview
- SupplierGeneTex
- Product NameHOOK2 antibody
- Delivery Days Customer9
- Application Supplier NoteWB: 1:500-1:3000. ICC/IF: 1:100-1:1000. IHC-P: 1:100-1:1000. *Optimal dilutions/concentrations should be determined by the researcher.Not tested in other applications.
- ApplicationsImmunoFluorescence, ImmunoPrecipitation, Western Blot, ImmunoCytoChemistry, ImmunoHistoChemistry, ImmunoHistoChemistry Paraffin
- CertificationResearch Use Only
- ClonalityPolyclonal
- Concentration1 mg/ml
- ConjugateUnconjugated
- Gene ID29911
- Target nameHOOK2
- Target descriptionhook microtubule tethering protein 2
- Target synonymsHK2, protein Hook homolog 2, h-hook2, hHK2, hook homolog 2
- HostRabbit
- IsotypeIgG
- Protein IDQ96ED9
- Protein NameProtein Hook homolog 2
- Scientific DescriptionHook proteins are cytosolic coiled-coil proteins that contain conserved N-terminal domains, which attach to microtubules, and more divergent C-terminal domains, which mediate binding to organelles. The Drosophila Hook protein is a component of the endocytic compartment.[supplied by OMIM]
- ReactivityHuman, Mouse
- Storage Instruction-20°C or -80°C,2°C to 8°C
- UNSPSC41116161

![HOOK2 antibody detects HOOK2 protein at cytoplasm by immunofluorescent analysis. Sample: HeLa cells were fixed in 4% paraformaldehyde at RT for 15 min. Green: HOOK2 protein stained by HOOK2 antibody (GTX115898) diluted at 1:500. Red: alpha Tubulin, a cytoskeleton marker, stained by alpha Tubulin antibody [GT114] (GTX628802) diluted at 1:1000. Blue: Hoechst 33342 staining. HOOK2 antibody detects HOOK2 protein at cytoplasm by immunofluorescent analysis. Sample: HeLa cells were fixed in 4% paraformaldehyde at RT for 15 min. Green: HOOK2 protein stained by HOOK2 antibody (GTX115898) diluted at 1:500. Red: alpha Tubulin, a cytoskeleton marker, stained by alpha Tubulin antibody [GT114] (GTX628802) diluted at 1:1000. Blue: Hoechst 33342 staining.](https://www.genetex.com/upload/website/prouct_img/normal/GTX115898/GTX115898_40302_20150410_IFA_w_23060519_941.webp)






